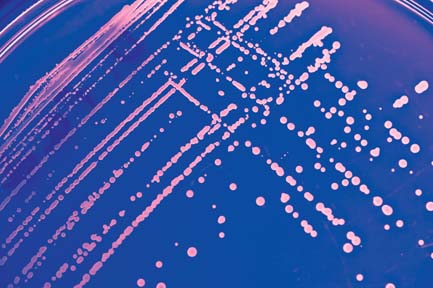

Tim Donohue among leaders of new United Microbiome Initiative
Tim Donohue, CALS bacteriology professor and director of the Great Lakes Bioenergy Research Center, is among a group of 18 scientists from around the world that last week called for an organized approach to harnessing the power of microbes to tackle many of the world’s most pressing problems.
Tim Donohue, CALS bacteriology professor and director of the Great Lakes Bioenergy Research Center, is among a group of 18 scientists from around the world that last week called for an organized approach to harnessing the power of microbes to tackle many of the world’s most pressing problems.
The group published two papers on Oct. 28, one in Nature and one in Science, summarizing their ideas and proposing a Unified Microbiome Initiative to supply key knowledge and techniques to address sustainable agriculture, chemical and energy production, climate change, disease and more.

A Unified Microbiome Initiative could help collect and process enormous amounts of information about hundreds or thousands of types of microbes that are born, eat, excrete, fight, die and evolve together — all the while making a fundamental difference in the environment they inhabit.
“What we need is an influx of people from other fields to work with the biochemists and microbiologists and engineers who have typically studied microbes in isolation,” Donohue says.
If scientists could accurately model communities of microbes, and anticipate how changes at the microscopic level make for changes visible on the human scale, they can anticipate problems and use microbes to create next-generation solutions to grand societal problems.
“That has enormous potential for the health of the planet and the health of people. It could make personalized medicine work. It could create new energy sources and be the catalyst for next-generation bio-based manufacturing. It could grow food and provide clean water,” Donohue says.
“It’s important that this be an international effort,” Donohue says. “This is a problem the United States has the brain power and the resources to be a leader in. But to do it right, it is critical that we take advantage of the expertise that exists around the globe. Because these are problems — medicine, energy, food — we face collectively.”
UW–Madison — where researchers are investigating the roles microbes play in lifelong health, plant productivity, wastewater treatment, manufacturing and more — is uniquely positioned to play a role in a concerted effort to broaden the way science studies and makes use of microbes.
“We have expertise in every arena that needs to be pulled in to contribute, beginning with a world-class cadre of microbiologists and a spirit of collaboration,” Donohue says. “Our medical school, veterinary school, strong engineering, agricultural experts, leaders in oceanography — if we can find a way here to connect teams of these people with researchers in analytics and computation, we can be a model for the country and the world.”
For more information, read the full UW-Madison news release.

